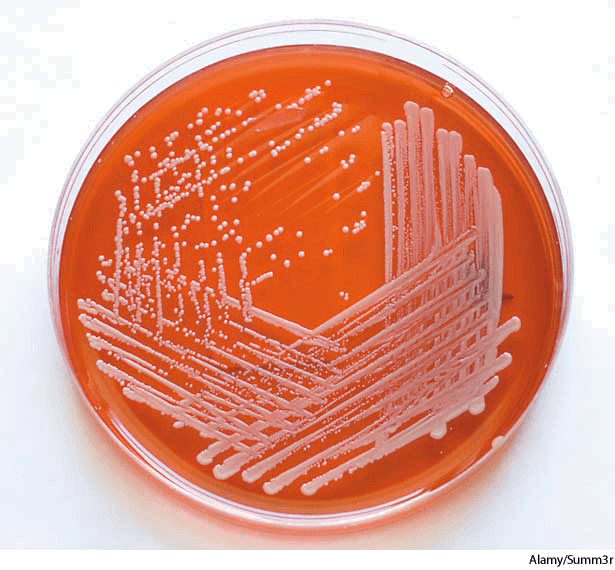

- A nutrient culture medium that is enriched with whole blood and used for the growth of certain strains of bacteria.血培养基:用全血培育的一种营养培养基,用于某些细菌的生长
- allantois什么意思翻译
- allargando什么意思翻译
- all-around什么意思翻译
- allative什么意思翻译
- allatives什么意思翻译
- allay什么意思翻译
- allayed什么意思翻译
- allayer什么意思翻译
- allaying什么意思翻译
- allays什么意思翻译
- all but什么意思翻译
- all clear什么意思翻译
- all-day什么意思翻译
- all ears什么意思翻译
- Allegany Community College什么意思翻译
- allegation什么意思翻译
- allegations什么意思翻译
- allege什么意思翻译
- allegeable什么意思翻译
- alleged什么意思翻译
- alleged什么意思翻译
- allegedly什么意思翻译
- alleger什么意思翻译
- alleges什么意思翻译
- Alleghenies什么意思翻译
- Allegheny College什么意思翻译
- Allegheny Mountains什么意思翻译
- Allegheny mountain spurge什么意思翻译
- Allegheny River什么意思翻译
- Allegheny spurge什么意思翻译
